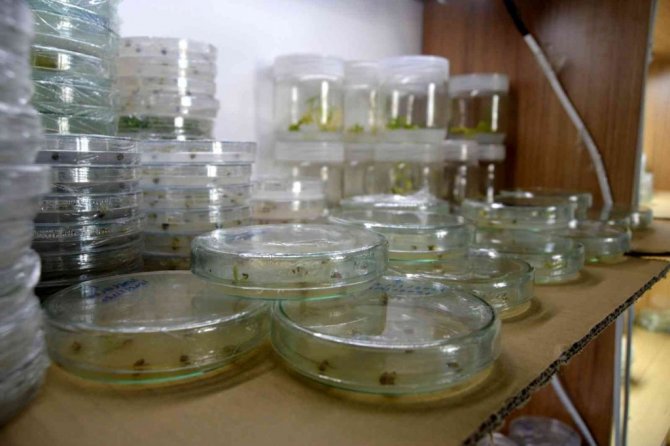

Türk bilim adamları, dünyayı saran kuraklık tehlikesine çare arıyor
Dünyayı kuraklık endişesi sararken Türk bilim adamları kuraklığa dirençli tohumlar üzerindeki çalışmalarını sürdürüyor.
Dünyayı kuraklık endişesi sararken Türk bilim adamları kuraklığa dirençli tohumlar üzerindeki çalışmalarını sürdürüyor.
Tüm dünyada baş gösteren kuraklık toplumun her kesimini endişelendiriyor. Ülkemizde özellikle yıl içerisinde etkisini hissettiren kuraklık nedeniyle üretimde rekolte ve verim kayıpları yaşandı. Su kaynaklarının kuruması ve bilinçsiz su kullanımı göllerin, barajların çekilmesine yol açtı. Sivas Bilim ve Teknoloji Üniversitesi Tarım Bilimleri ve Teknoloji Fakültesi Dekanı Prof. Dr. Tolga Karaköy ve ekibi kuraklığa dirençli tohumlar üzerinde ki çalışmalarını aralıksız sürdürüyor. Çalışmaları ile ilgili bilgi veren Karaköy, iklim değişikliğiyle birlikte gelecekte oluşabilecek kuraklığın neden olacağı sıkıntı ve sorunlara değindi. Karaköy, açıklamasında gıda temini noktasında da açıklamalarda bulunarak üretim ve ıslah çalışmalarının acilen planlanması gerektiğini söyledi.
Gelecekte gıda temininde sıkıntılar yaşanacağı öngörülüyor
Sivas Bilim ve Teknoloji Üniversitesi Tarım Bilimleri ve Teknoloji Fakültesi Dekanı Prof. Dr. Tolga Karaköy, "Küresel noktada baktığımızda bir iklim değişikliği söz konusu. Bu iklim değişikliğini detaylı olarak incelediğimizde de gelecek yıllarda kuraklık tehlikesinin olabileceği öngörülüyor. Buna hem kış kuraklığı hem yaz kuraklığı olarak olaya bakmak gerekiyor. 2020-2021 yetiştiricilik programına bakacak olursak bu kuraklık kendisini iyiden iyiye hissettirdi. Özellikle bu yıl tahıllar genellikle yağışlara bağlı olarak ekiliyor ve buna baktığımızda Nisan ve Mayıs ayında Sivas ili genelinde yağışın düşmediğini görüyoruz. Bu çok ciddi bir şekilde verim ve kalite kayıplarına yol açabilmektedir. Su kaynaklarının kuraklığa bağlı olarak azalması, göletler ve barajların dolmaması, yer altı su kaynaklarının daha da çekilmesine neden olmakta. Özellikle sulu tarım yaptığımız alanlarda üretimimizi çok ciddi noktada sınırlandırmaktadır. Bu konuda çeşitli çalışmalar bizde yapmaktayız. Dünyaya baktığımızda dünyada ki bilim insanları bu konularla ilgili olarak gelecekte iklim değişikliklerinin bu şekilde devam ettiği sürece kuraklık ve gıda temini konusunda çok ciddi sıkıntı ve sorunların oluşabileceğini de öngörmektedirler" dedi.
Üretim planlaması acilen yapılmalı
Prof. Dr. Karaköy, dünya nüfusunu besleyecek şekilde üretim ve ıslah çalışmalarının acilen planlanması gerektiğini belirterek, "Dünya nüfusu çok hızlı bir şekilde artmakta. Artan dünya nüfusunun beslenebilmesi için biz şuan aldığımız ürün rekoltesinin çok daha üzerine çıkabilmemiz gerekiyor. Ürün rekoltesinin üzerine çıkabilmek adına da bizi sınırlandıran bitkiler açısından stres koşullarına yol açan kuraklık ve soğuk gibi fizyolojik faktörlere göre mutlaka biz çalışmalar yapmak durumundayız. Aslında baktığımızda dünyada şuan da kuraklığa ve çevresel değişikliğe bağlı olarak oluşan bir sıkıntı ve problemin olmadığını düşünüyorum ancak oluşabilecek bir problem var. Şuanda dünyadaki insanların beslenme konusunda temel problemimiz mevcut kaynakların adil ve eşit dağıtılamamasından kaynaklanmaktadır. Özellikle Afrika bölgesine baktığımızda 5-10 saniyede bir insanların açlıktan öldüğünü görüyoruz. Burada en önemli problem gelişmiş ülkelerdeki gıda israfının önüne geçebilmek ve bu konuda adil bir dağıtımla şuanda bunun üstesinden gelebiliriz. Ancak gelecekte çevresel faktörlerin ve iklimsel değişikliklerin olmasıyla beraber bizim ürün desenimizde yetiştiricilik anlamında dünyanın her yerinde mutlaka değişiklikler olması gerekiyor. Biz komşularımızla beraber yaklaşık 600 milyon nüfusu da besleyecek şekilde bir üretim planlamasının acilen yapılması buna yönelik olarak da ıslah çalışmalarının planlanması gerektiğine inanıyoruz" şeklinde konuştu.
Islah çalışmaları sürüyor
Prof. Dr. Tolga Karaköy, kuraklığa dirençli tohumlar üzerinde ıslah çalışmalarını sürdürdüklerini söyleyerek, "Bizlerde şuanda özellikle tahıllarda çalışmalarımızı sürdürüyoruz. Biliyorsunuz buğday stratejik bir üründür. Buğdaya yönelik olarak tahıllar, arpa, yulaf, tritikale gibi bitkilere yönelik olarak ıslah çalışmalarımız rutin olarak devam ediyor. Her yıl mutlaka bunlarla ilgili melezlemeler, laboratuvar çalışmalarını yürüterek özellikle markıra dayalı çalışmalar yapıyoruz. Islah programlarımızı oluşturmuş durumdayız" ifadelerini kullandı.

Türkçe karakter kullanılmayan ve büyük harflerle yazılmış yorumlar onaylanmamaktadır.